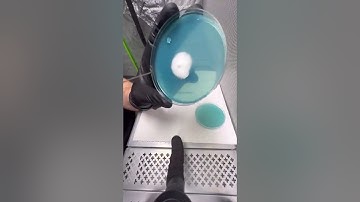
Here’s a tip, take it or leave it episode 10. Noc loop coring tool! #treediggsmyco #heartshroom

⬇ DOWNLOAD NOW
Kalau muncul iklan pop-up, tutup lalu klik tombol kembali
Download lagu Troll - Think Quick ;) When grow pellets hide in the corner secara gratis hanya untuk keperluan promosi. Dukung artis favorit kamu dengan membeli musik original di iTunes atau platform resmi lainnya.
 Agma.io *EXTREME POWERUPS EDIT* "WHOS THE BEST PLAYER"? MONTAGE | Laz
Agma.io *EXTREME POWERUPS EDIT* "WHOS THE BEST PLAYER"? MONTAGE | Laz
 Black Cat Power Destruction - #agma
Black Cat Power Destruction - #agma
Here’s a tip, take it or leave it episode 10. Noc loop coring tool! #treediggsmyco #heartshroom
Here’s a tip, take it or leave it episode 10. Noc loop coring tool! #treediggsmyco #heartshroom
 Agma io /power spam/
Agma io /power spam/
 The Agma.io Master CR7💫 | Best Reverses
The Agma.io Master CR7💫 | Best Reverses
 This Simple Substance Gets Rid of MICE & RATS in SECONDS
This Simple Substance Gets Rid of MICE & RATS in SECONDS
 Agma io power spam 😎😎😎
Agma io power spam 😎😎😎
 Kreature Feature - Refill (Official Music Video)
Kreature Feature - Refill (Official Music Video)